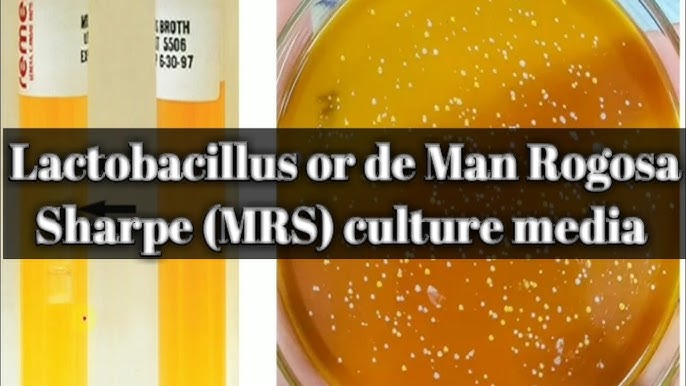

16+ Lb Medium Recipe

Media Recipes


Smoke A Traeger Brisket Like A Boss Hilda S Kitchen Blog

Tina S Spring Party Facebook
Farmina N D Ancestral Grain Chicken And Pomegranate Senior Medium And Maxi Dog Food Ofypets

Thanksgiving Menu 2019

Lb Medium Preparation Youtube

Saponify 4lb Charcoal Melt And Pour Soap Base Pure Skin Cleansing Activated Charcoal Soap Base Easy To Use Glycerin Soap Base For Soap Making 4 Lb Charcoal

16 Healthy Ground Meat Recipes Paleo Aip Friendly Food By Mars

Amazon Com Stella Chewy S Raw Coated Premium Kibble Cat Food Grain Free Protein Rich Meals Cage Free Duck Recipe 5 Lb Bag Pet Supplies

Mexican Shrimp Burritos With A Sour Cream Cheese Sauce Recipe Cooking Seafood Shrimp Recipes For Dinner Seafood Recipes

Amazon Com Stella Chewy S Raw Blend Premium Kibble Cat Food Grain Free Protein Rich Meals Cage Free Poultry Recipe 2 5 Lb Bag Pet Supplies

Smoke A Traeger Brisket Like A Boss Hilda S Kitchen Blog

Adult Chicken Recipe Cat Food

Media Recipes

Want Some Grade A Cheese Respec Ekun To A Slayer Deliver R Pathfinder Kingmaker

Super Simple One Pan Oven Roasted Whole Chicken Rice Food For A Year

Saponify 2lb Aloe Melt And Pour Soap Base Skin Enhancing Pure Aloe Vera Soap Base Easy To Use Glycerin Soap Base For Soap Making 2 Lb Aloe Melt
Lb Medium Preparation Youtube